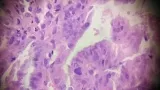

- Компании
- Takeda. О компании, буклеты, каталоги, контакты
- Olympus. О компании, буклеты, каталоги, контакты
- Boston Scientific. О компании, буклеты, каталоги, контакты
- Pentax. О компании, буклеты, каталоги, контакты
- Fujifilm & R-Farm. О компании, буклеты, каталоги, контакты
- Erbe. О компании, буклеты, каталоги, контакты
- Еще каталоги
- Мероприятия
- Информация
- Обучение
- Классификации
- Атлас
- Quiz
- Разделы
- Пациенту
QR-код этой страницы
Для продолжения изучения на мобильном устройстве ПРОСКАНИРУЙТЕ QR-код с помощью спец. программы или фотокамеры мобильного устройства
Случайный выбор
данная функция, случайным образом выбирает информацию для Вашего изучения,
запустите выбор нажав кнопку ниже

Обратная связь
Напишите нам
Рекомендуемые статьи
Синдром Бергмана
расстройство сердечной деятельности с изменениями ЭКГ при рефлюкс-эзофагите и аксиальной грыже
При эндоскопическом исследовании в случае бронхоэктазов в стадии ремиссии выявляется
частично диффузный бронхит I степени воспаления
Работаем и учимся при поддержке
Партнеры

Вы находитесь в разделе предназначенном только для специалистов (раздел для пациентов по ссылке). Пожалуйста, внимательно прочитайте полные условия использования и подтвердите, что Вы являетесь медицинским или фармацевтическим работником или студентом медицинского образовательного учреждения и подтверждаете своё понимание и согласие с тем, что применение рецептурных препаратов, обращение за той или иной медицинской услугой, равно как и ее выполнение, использование медицинских изделий, выбор метода профилактики, диагностики, лечения, медицинской реабилитации, равно как и их применение, возможны только после предварительной консультации со специалистом. Мы используем файлы cookie, чтобы предложить Вам лучший опыт взаимодействия. Файлы cookie позволяют адаптировать веб-сайты к вашим интересам и предпочтениям.
Я прочитал и настоящим принимаю вышеизложенное, хочу продолжить ознакомление с размещенной на данном сайте информацией для специалистов.

.jpg)



.jpg)












Комментарии